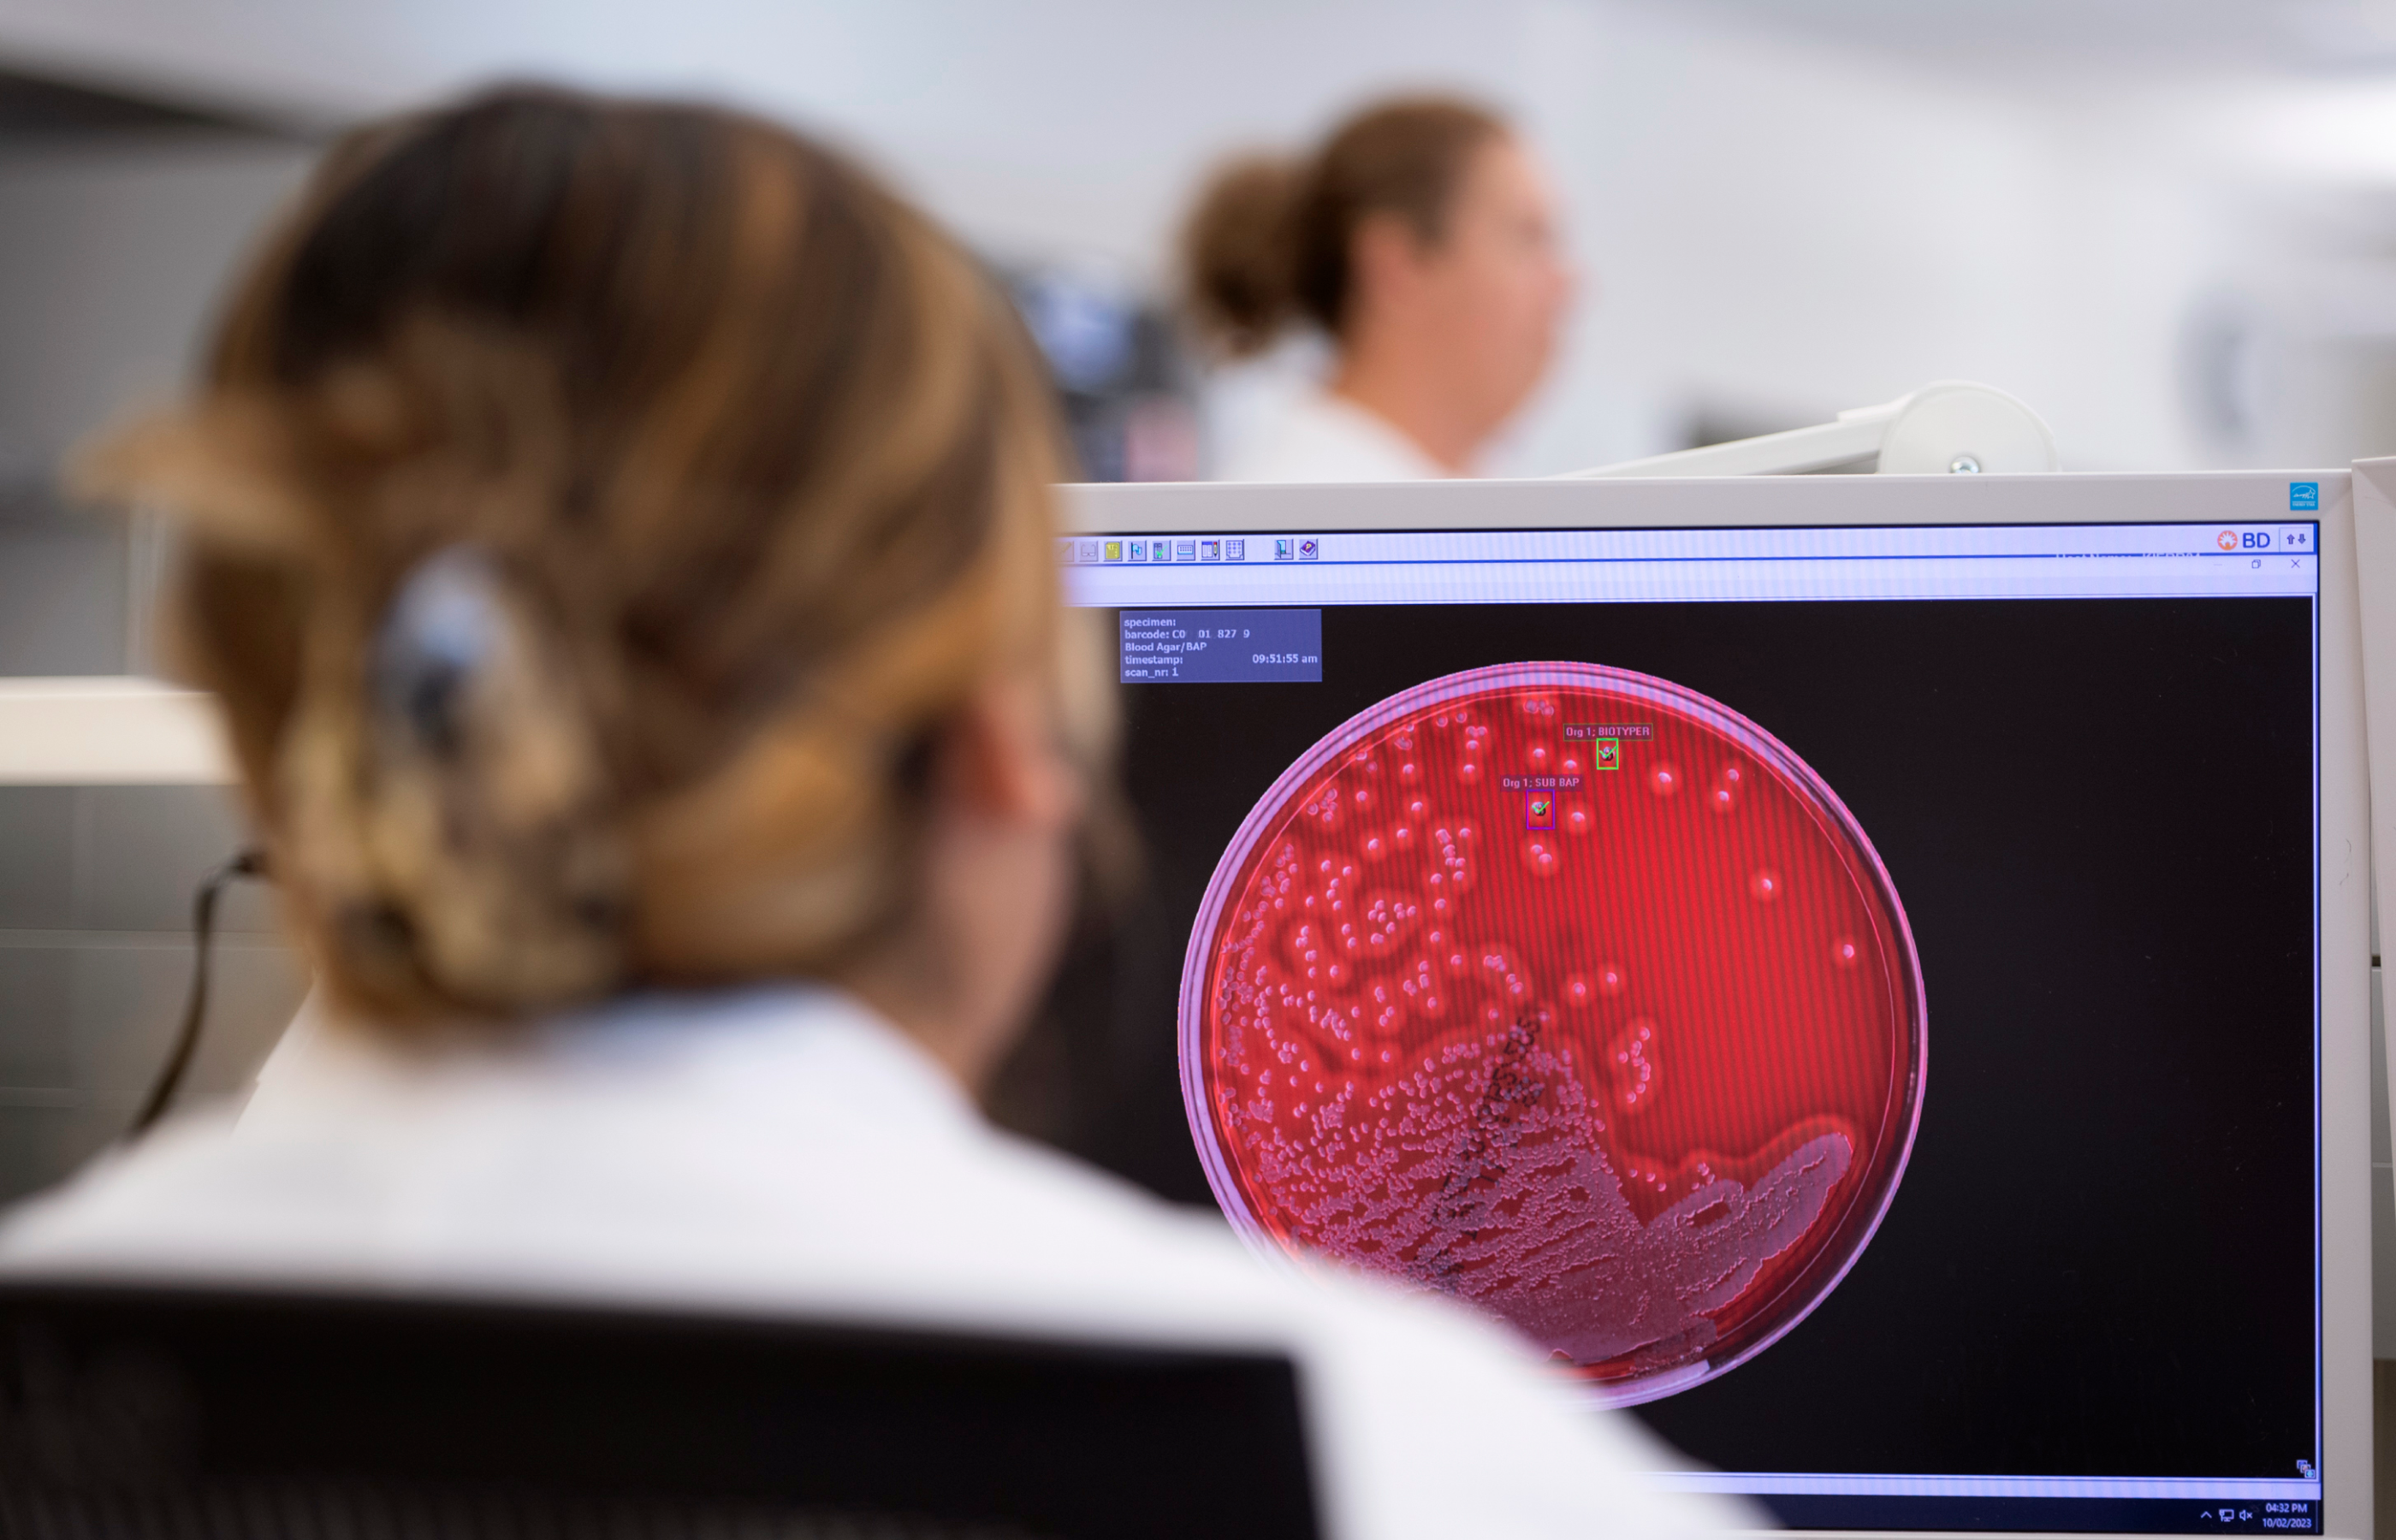

Laboratory Test Library
The following is a list of lab tests provided by Novant Health New Hanover Regional Medical Center lab services locations. Tests are listed alphabetically by name.
Select a test to view details like:
- Alternate name
- Testing availability
- Acceptable container types
- Special handling instructions
- Patient preparation instructions
- Reasons a collected specimen might be rejected
All links open PDF documents in a new browser tab.

Get in touch.
Interested in local, quality, cost-effective laboratory testing for your facility? Submit our contact form today. We will respond within five business days to discuss solutions that meet your individual needs.